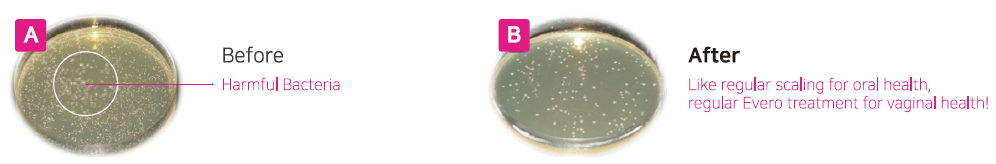

Finexel Fractional Co2 Laser
Fractional CO2 laser, due to its high precision and efficiency, is widely used in the fields of medicine, aesthetics, and rejuvenation. In addition to its surgical applications for precise incisions, the controlled injuries created by fractional lasers through micro-thermal zones in the skin stimulates the natural tissue repair process, leading to collagen production and skin cell regeneration. Moreover, CO2 laser plays a significant role in gynecology, dentistry, and soft tissue treatments, offering a safe and effective solution for therapeutic and cosmetic applications.
Expand CO2 laser option for gynecologic use
Finexel is an innovative laser device specifically designed to support women’s health across a range of therapeutic applications. Currently, fractional CO₂ laser therapy is gaining increasing importance as an effective treatment modality for managing HPV-related lesions. Given the high prevalence of HPV and its role in causing precancerous and cancerous changes in the cervix, vagina, and vulva, ablative treatments such as laser ablation offer a minimally invasive, precise approach with minimal damage to surrounding healthy tissue.
Fractional CO₂ laser creates controlled microscopic ablations that stimulate tissue regeneration and eliminate infected or dysplastic cells without causing extensive scarring or functional impairment. This method is particularly valuable in younger patients for whom preserving cervical and genital structure and function is critical. Compared to other treatment options, it offers significant advantages in both mechanism of action and clinical outcomes. It does not negatively affect fertility, has a low recurrence rate, and allows highly accurate control over the depth and extent of tissue destruction.
In gynecologic laparoscopic surgeries, CO₂ laser also serves as a precise cutting and vaporization tool for soft tissues. It’s focused and controllable energy enables contact-free procedures, reducing bleeding, limiting thermal damage, and improving surgical visibility. In cases such as endometriosis, pelvic adhesions, or superficial lesions of the ovaries and uterus, CO₂ laser can be an effective alternative to mechanical or electrosurgical instruments.
Moreover, advanced fractional laser technology can stimulate collagen production in soft tissues, promoting better structural regeneration of the vaginal wall and skin, helping women regain comfort and confidence. The Finexel device holds CE Medical certification in Europe and FDA approval in the United States, and leverages cutting-edge technology to deliver outstanding clinical results. Equipped with multiple handpieces, it ensures safe and reliable performance, offering ideal therapeutic outcomes for gynecology specialists.
Guarantees consistent output and uniform spot size with a high-quality pulse via an excellent combination of hardware such as the power board, high voltage transformer, and laser tube.
Delivery of more focused laser with minimum beam spot size which promotes very rapid healing, lower pain rate, shortens down time and reduces thermal damage on adjacent tissues.
Having a powerful Ultra-Pulse mode with exceptional higher peak power and minimum pulse duration, guarantees char-free and effective treatment for patient.
User-friendly and easier operating system
Variety of scan types, density, and size setting functions allow for the optimal result in the broad range of treatments.
Reliable preset program and safe recommended parameters with low risk of scarring, backed by long-term clinical research and tests conducted by several key specialized physicians.
Optimized Vaginal handpiece designed for safe treatment and better result.
Quick Treatment :10 mins per 1 session with less pain and side effect. Post procedure, most patients can return to their normal routine with little to no downtime.
Thermal stimulation of entire vaginal wall layer
Immediately after treatment, shrinkage of the vaginal skin fibers occurs. In addition, collagen growth is promoted and the vaginal wall becomes resilient and thick. Changed Vaginal structure after treatments makes its whole conditions better.
Effect of Laser Treatment Collagen Stimulation
- Vaginal Remodeling
- Vaginal Dryness
- Sexual Dissatisfaction
- Pelvic Organ Prolapse
- Urinary Incontinence

Bacteria Reduction
there is emerging evidence that vaginal fractional CO₂ laser therapy can positively impact bacterial vaginitis, especially in recurrent cases. Several studies have explored its role in modulating vaginal pH, enhancing lactobacilli populations, and reducing recurrence rates.
All the indication of Finexel are available.
Especially Evero is used for gynecology field.
Fractional Indications
- Labia major reformation
- Pudenda Reshaping
- Steria & stretch marks
- Traumatic Scars
- Cesarean Scar improvement
- Labia Brightening
- Vaginal Tightening & Rejuvenation
- Vaginal Atrophy
- Vaginal Laxity
Surgical Indications
- CIN ablation
- VAIN ablation
- VIN ablation
- Condyloma & Warts
- Mole
- Labiaplasty
- Conization
- Different Laparoscopic surgeries ( Endometriosis, Hysterectomy ,etc.)